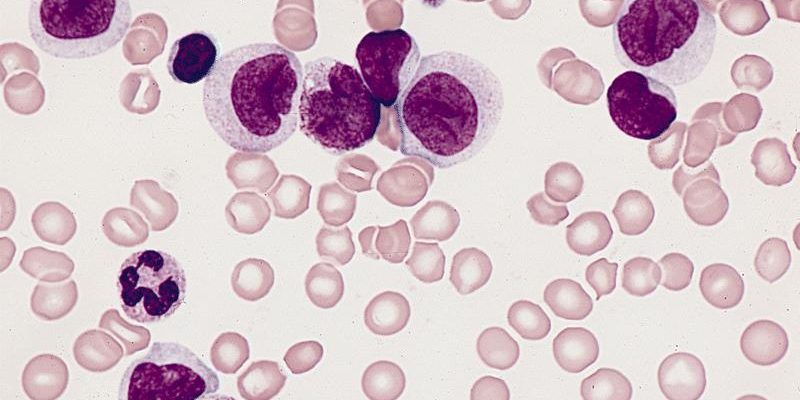

Panel for diagnosis Acute myelomonocytic leukemia
CD45, CD33, HLA-DR, CD117, CD34, CD13, CD15, CD36, CD11b, CD14, CD64
لوسمی میلومونوسیتی حاد (AMML)، که یک زیرگروه از لوسمی میلوئیدی حاد (AML) با تمایز هم به سمت خط میلوئیدی و هم مونوسیتی است، توسط مجموعهای متنوع از مارکرهای سطح سلولی شناسایی و تشخیص داده میشود. این مارکرها به پزشکان کمک میکنند تا تفاوتهای بین سلولهای لوکمیایی و سایر انواع سلولهای خونی را شناسایی کنند و تشخیص دقیقی از نوع خاص لوسمی ارائه دهند. در ادامه، به معرفی و توضیح مارکرهای استفاده شده در پنل تشخیصی برای AMML میپردازیم:
CD45: معروف به آنتیژن لکوسیتی مشترک، بر روی تقریباً تمام سلولهای خونی بیان میشود و به عنوان یک مارکر پایه برای شناسایی سلولهای لوکمیایی استفاده میشود.
CD33: مارکری میلوئیدی که در اکثریت سلولهای میلومونوسیتی و در بسیاری از موارد AML مثبت است.
HLA-DR: یک آنتیژن کلاس II مرتبط با MHC است که بر روی بسیاری از سلولهای ایمنی بیان میشود و میتواند در تشخیص برخی زیرگروههای AML مثبت باشد.
CD117 (c-Kit): یک تیروزین کیناز رسپتوری که بر روی سلولهای بنیادی و پیشسازهای هماتوپویتیک بیان میشود و میتواند در شناسایی AML مفید باشد.
CD34: مارکری برای سلولهای بنیادی و پیشسازهای هماتوپویتیک که در برخی موارد AML بیان میشود.
CD13 و CD15: مارکرهای میلوئیدی که در تشخیص AMML کاربرد دارند.
CD36: یک گلیکوپروتئین روی سلولهای مونوسیتی و برخی سلولهای دیگر که میتواند در تشخیص AMML مفید باشد.
CD11b و CD14: مارکرهای مرتبط با سلولهای مونوسیتی که در تشخیص AMML کاربرد دارند.
CD64: یک رسپتور برای Fc گاما که بر روی سلولهای مونوسیتی بیان میشود و در تشخیص AMML مفید است.